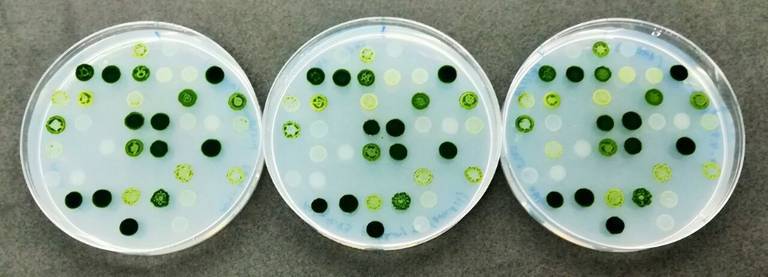

Investigadoras de la UHU lideran un proyecto que aísla 60 tipos de microalgas para uso alimenticio
Investigadoras del proyecto inm ALGARED+, liderado por la Universidad de Huelva, han aislado más de 60 especies de microalgas para uso alimenticio y nutracéutico en colaboración con expertos de la Universidades del Algarve, Córdoba, empresas y centros tecnológicos. Este se enmarca dentro del Programa Cooperación Transfronteriza España-Portugal (POCTEP) de INTERREG V-A España-Portugal 2014-2020.
Según ha manifestado Rosa León, coordinadora de ALGARED +, el proyecto buscará aplicabilidad en el ámbito de la salud, energía, los cosméticos y la acuicultura, entre otras utilidades. “Nuestro objetivo es crear una base de especies de microalgas para conocer cuáles son las más aptas para cada uno de los campos a estudio”, ha subrayado León.
Así, los ensayos en laboratorio con las especies aisladas conducirán –según la propia investigadora- a observar su potencialidad como piensos para peces o en la elaboración de principios activos como suplementos alimenticios.
Como resultado preliminar del proyecto ALGARED+, los distintos grupos de investigación han publicado nueve artículos en revistas de impacto. El último, relacionado con el hallazgo de bacterias y arqueas (Salinibacter ruber, Halorubrum y Haloquadratum) en las salinas de las Marismas del Odiel.
En ALGARED + participan el IFAPA Centro El Toruño, el ICMAN-CSIC, las empresas IPMA, Necton, Sea4Us y el centro tecnológico CTAQUA.